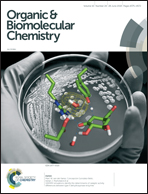

Tuning the fluorescence of tetraphenylethylene in dilute solutions via modulating multiple-hydrogen-bonding interactions between a Hamilton receptor and cyanuric acid†
Abstract
Four Hamilton receptors and four cyanuric acid modules were introduced into the tetraphenylethylene skeleton to form HTPE and CTPE, respectively. Upon 1 : 1 mixing of HTPE and CTPE in apolar dilute solution, a self-assembled supramolecular network was formed via multiple intermolecular hydrogen bonding interactions. The intramolecular rotation of phenyls in TPE skeletons was restricted, and thus the system became highly luminescent. Upon the addition of a hydrogen bonding competitive solvent to destroy the network, the fluorescence emission was substantially quenched. Besides, the fluorescence of the system could be further tuned by the addition of Cu2+ and other metal ions.

- This article is part of the themed collection: Supramolecular chemistry in OBC

Please wait while we load your content...
Please wait while we load your content...